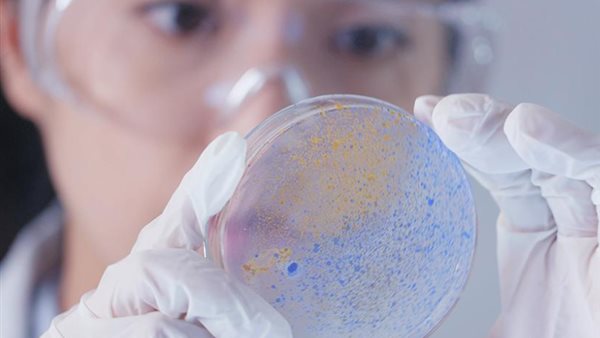
اليوم العالمي للمرأة

تساهم في التنمية المستدامة.. الأمم المتحدة تحتفل باليوم العالمي للمرأة في ميدان العلوم
تحتفل الأمم المتحدة بـ اليوم العالمي للمرأة والفتاة في ميدان العلوم في 11 فبراير من كل عام، تقديرًا للمجهودات النسائية للباحثات في مجال علوم التكنولوجيا ودعم تمكين المرأة في سوق العمل المهني والمجال العلمي ومكافحة تغير المناخ؛ مما يساهم في تحقيق أهداف التنمية المستدامة على المستوى الدولي.
نظرة جديدة في اليوم العالمي للمرأة في ميدان العلوم
وأوضحت الأمم المتحدة أن سبب احتفالها بهذا اليوم؛ من أجل زيادة عدد النساء العاملات في هذه المجالات العلمية والتكنولوجية، مما يؤدي إلى التنوع في الأبحاث وتوسيع مجموعة الباحثين الموهوبين، وجلب وجهات نظر جديدة وإبداعات ميدان العلوم.
ويعتبر هذا اليوم بمثابة تذكير بأن للنساء والفتيات لهن دور حاسم في مجتمعات العلوم والتكنولوجيا، وضرورة تعزيز مشاركتهن للتصدي أمام التحديات التي يواجهنها العالم من أجل التنمية المستدامة وأزمات تغير المناخ.
وأكدت الأمم المتحدة أن مجالات العلوم والتكنولوجيا والهندسة والرياضيات تُعد ذات أهمية كبيرة للاقتصادات الوطنية، إلا أن معظم الدول لم تحقق المساواة بين الجنسين في العمل بهذه المجالات حتى الآن، موضحة أهمية تلك الاحتفالية في مناقشة القيادة النسائية في تحقيق الركائز الأساسية للتنمية المستدامة، والتي من أبرزها الرخاء الاقتصادي، والعدالة الاجتماعية، والسلامة البيئية.
تمكين المرأة
ورغم أن المرأة أحرزت تقدمًا هائلًا للرفع من مشاركتها في التعليم العالي، إلا أنها ما زالت غير ممثلة بشكل كاف في هذه المجالات، ومازالت قضايا المساواة بين الجنسين هي الدافع الجوهري خلف تقدير دور المرأة المميز في كافة الاحتفالات العالمية، حيث أن المساواة بين الجنسين وتمكين المرأة سيسهمان إسهامًا مهمًا في التنمية الاقتصادية العالمية وإحراز تقدم في جميع الأهداف العالمية التي من المفترض أن تتحقق بحلول العام 2030.
وأشارت الأمم المتحدة، إلى أن 20 ديسمبر 2013 كان اليوم التي اعتمدت فيه الجمعية العامة قرارًا بشأن تقدير دور المرأة في مجال العمل التكنولوجي من أجل التنمية، حيث أن تمكين المرأة والفتاة في جميع الفئات العمرية من الحصول على فرص العمل التكنولوجي والتعليم والتدريب المهني، هو ضرورة لتحقيق المساواة بين الجنسين وتمكين المرأة والفتاة، لتحتفل المنظمة الدولية باليوم العالمي للمرأة والفتاة في ميدان العلوم.



















